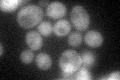
YOR138C
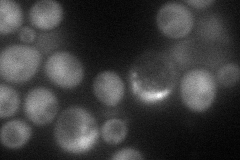
YOR138C
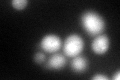
YOR138C
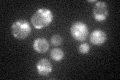
YOR138C

View description
Protein involved in regulation of Rsp5p, which is an essential HECT ubiquitin ligase; has a WW domain consensus motif of PPPSY (residues 131-135) that mediates binding of Rsp5p to Ubp2p; contains an UBA domain
Localization:
Intensity:
Fold change:
Significance:
-
C’ GFP library in SD
cytosol42.48 -
N' NOP1pr-GFP in SD
cytosol79.8746 -
N' TEF2pr-mCherry in SD

nucleus79.2377 -
N' NATIVEpr-GFP in SD

cytosol36.4603 -
N' TEF2pr-VC and Cyto-VN in SD

cytosol44.4449 -
C’ GFP library in SD+DTT
cytosol60.491.42Yes -
C’ GFP library in SD+H2O2

cytosol56.931.34Yes -
C’ GFP library in Starvation Media
punctateN/AN/AYes -
C’ GFP library on the background of Pup2-DaMP

cytosol -
C’ GFP library on the background of CCT mutant

cytosol49.51181.16542No
